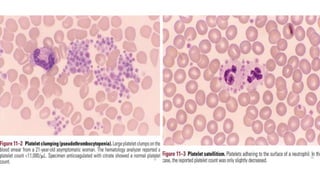
Platelet disorders- qualitative and quantitative | PPTX

Live your best life through substantial collections of lifestyle-focused ppt - quantitative platelet disorders powerpoint presentation - id:73502 photographs. encouraging positive living via photography, images, and pictures. designed to inspire positive life choices. Browse our premium ppt - quantitative platelet disorders powerpoint presentation - id:73502 gallery featuring professionally curated photographs. Suitable for various applications including web design, social media, personal projects, and digital content creation All ppt - quantitative platelet disorders powerpoint presentation - id:73502 images are available in high resolution with professional-grade quality, optimized for both digital and print applications, and include comprehensive metadata for easy organization and usage. Our ppt - quantitative platelet disorders powerpoint presentation - id:73502 gallery offers diverse visual resources to bring your ideas to life. Diverse style options within the ppt - quantitative platelet disorders powerpoint presentation - id:73502 collection suit various aesthetic preferences. The ppt - quantitative platelet disorders powerpoint presentation - id:73502 archive serves professionals, educators, and creatives across diverse industries. Instant download capabilities enable immediate access to chosen ppt - quantitative platelet disorders powerpoint presentation - id:73502 images. Cost-effective licensing makes professional ppt - quantitative platelet disorders powerpoint presentation - id:73502 photography accessible to all budgets. Professional licensing options accommodate both commercial and educational usage requirements.